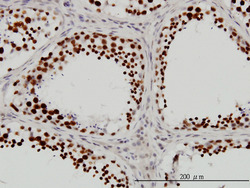

Antibody data
- Antibody Data
- Antigen structure
- References [6]
- Comments [0]
- Validations
- Western blot [1]
- Immunocytochemistry [1]
- Immunohistochemistry [1]
Submit
Validation data
Reference
Comment
Report error
- Product number
- H00001660-M01 - Provider product page

- Provider
- Abnova Corporation
- Proper citation
- Abnova Corporation Cat#H00001660-M01, RRID:AB_489984
- Product name
- DHX9 monoclonal antibody (M01), clone 3G7
- Antibody type
- Monoclonal
- Description
- Mouse monoclonal antibody raised against a partial recombinant DHX9.
- Antigen sequence
MGDVKNFLYAWCGKRKMTPSYEIRAVGNKNRQKFM
CEVQVEGYNYTGMGNSTNKKDAQSNAARDFVNYLV
RINEIKSEEVPAFGVASPPP- Isotype
- IgG
- Antibody clone number
- 3G7
- Storage
- Store at -20°C or lower. Aliquot to avoid repeated freezing and thawing.
Submitted references Cellular RNA binding proteins NS1-BP and hnRNP K regulate influenza A virus RNA splicing.
Roles of the linker region of RNA helicase A in HIV-1 RNA metabolism.
In vitro and in vivo analysis of the interaction between RNA helicase A and HIV-1 RNA.
Coordinate roles of Gag and RNA helicase A in promoting the annealing of formula to HIV-1 RNA.
Functional proteomic analysis of promyelocytic leukaemia nuclear bodies in irradiation-induced MCF-7 cells.
RNA helicase A interacts with RISC in human cells and functions in RISC loading.
Tsai PL, Chiou NT, Kuss S, GarcĂa-Sastre A, Lynch KW, Fontoura BM
PLoS pathogens 2013;9(6):e1003460
PLoS pathogens 2013;9(6):e1003460
Roles of the linker region of RNA helicase A in HIV-1 RNA metabolism.
Xing L, Niu M, Zhao X, Kleiman L
PloS one 2013;8(11):e78596
PloS one 2013;8(11):e78596
In vitro and in vivo analysis of the interaction between RNA helicase A and HIV-1 RNA.
Xing L, Niu M, Kleiman L
Journal of virology 2012 Dec;86(24):13272-80
Journal of virology 2012 Dec;86(24):13272-80
Coordinate roles of Gag and RNA helicase A in promoting the annealing of formula to HIV-1 RNA.
Xing L, Liang C, Kleiman L
Journal of virology 2011 Feb;85(4):1847-60
Journal of virology 2011 Feb;85(4):1847-60
Functional proteomic analysis of promyelocytic leukaemia nuclear bodies in irradiation-induced MCF-7 cells.
Liu J, Song Y, Tian B, Qian J, Dong Y, Liu J, Liu B, Sun Z
Journal of biochemistry 2010 Dec;148(6):659-67
Journal of biochemistry 2010 Dec;148(6):659-67
RNA helicase A interacts with RISC in human cells and functions in RISC loading.
Robb GB, Rana TM
Molecular cell 2007 May 25;26(4):523-37
Molecular cell 2007 May 25;26(4):523-37
No comments: Submit comment
Supportive validation
- Submitted by
- Abnova Corporation (provider)
- Main image

- Experimental details
- DHX9 monoclonal antibody (M01), clone 3G7 Western Blot analysis of DHX9 expression in Hela S3 NE ( Cat # L013V3 ).
Supportive validation
- Submitted by
- Abnova Corporation (provider)
- Main image

- Experimental details
- Immunofluorescence of monoclonal antibody to DHX9 on HeLa cell. [antibody concentration 10 ug/ml]
- Validation comment
- Immunofluorescence
- Protocol
- Protocol
Supportive validation
- Submitted by
- Abnova Corporation (provider)
- Main image
- Experimental details
- Immunoperoxidase of monoclonal antibody to DHX9 on formalin-fixed paraffin-embedded human testis. [antibody concentration 3 ug/ml]
- Validation comment
- Immunohistochemistry (Formalin/PFA-fixed paraffin-embedded sections)
- Protocol
- Protocol